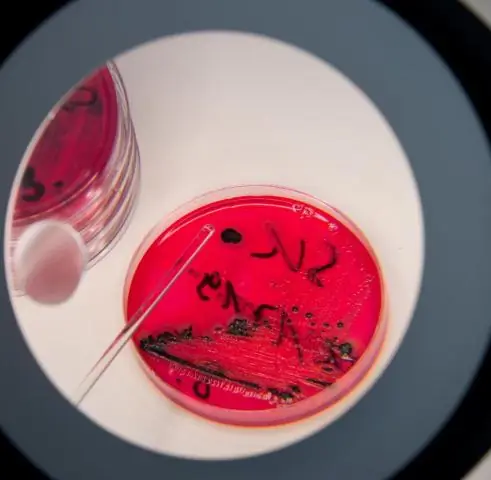
Природа сальмонеллы меняется, и это становится все более жестоким

Сальмонелла проявляет себя в Мичигане, и, согласно новому исследованию Мичиганского государственного университета, это может быть моделью того, что происходит в других штатах.
Исследование, опубликованное в журнале Frontiers in Medicine, документирует значительный всплеск устойчивых к антибиотикам штаммов и, следовательно, более длительное пребывание в больнице, поскольку врачи работают над лечением растущего количества вирулентных патогенов.
«Если вы сегодня заразитесь сальмонеллезом, устойчивым к антибиотикам, вы, скорее всего, будете госпитализированы дольше, и вам потребуется больше времени для выздоровления», - сказал Шеннон Мэннинг, профессор Фонда МГУ на кафедре микробиологии. и молекулярной генетики и старший автор исследования.«Нам нужны более совершенные методы обнаружения на клиническом уровне для раннего выявления устойчивых патогенов, чтобы мы могли лечить их правильными препаратами с первого раза».
Потеря дня или более из-за неправильного диагноза или неправильного лечения приводит к ухудшению симптомов. Врачи могут уничтожить субпопуляцию восприимчивых бактерий, но те, которые устойчивы, становятся сильнее, добавила она.
Сальмонелла представляет собой разнообразную группу бактериальных патогенов, вызывающих пищевые инфекции. У инфицированных пациентов часто развивается диарея, тошнота, рвота и боль в животе, хотя некоторые инфекции протекают тяжелее и могут быть опасными для жизни.
Когда дело доходит до лечения, каждый штамм по-разному реагирует на ряд антибиотиков, доступных для назначения врачами. Поэтому очень важно сделать все правильно с первого раза.
В частности, в Мичигане врачи наблюдают больше штаммов, устойчивых к ампициллину, обычному антибиотику, назначаемому для лечения сальмонеллы. Множественная лекарственная устойчивость, или устойчивость к более чем трем классам антибиотиков, также увеличилась в Мичигане и может еще больше усложнить планы лечения пациентов.
Мы до сих пор не уверены, почему это происходит; возможно, эти антибиотики были назначены чрезмерно в медицине и ветеринарии, и что наличие генов устойчивости позволило этим бактериям расти и процветать в присутствии антибиотики», - сказал Мэннинг. «В каждом штате есть свои проблемы с устойчивостью к антибиотикам. Важно, чтобы медицинские работники оставались бдительными в отношении постоянно меняющихся моделей устойчивости сальмонеллы и других патогенов пищевого происхождения, а не искали общенациональное решение».
Исторически сальмонелла поражала маленьких детей и пожилых людей, но теперь наблюдается рост заболеваемости среди взрослых, что позволяет предположить, что эпидемиология инфекций в Мичигане изменилась.
Изучая отдельные штаммы сальмонеллы, группа ученых обнаружила, что у пациентов с Typhimurium вероятность развития устойчивых инфекций выше, чем у пациентов, инфицированных в осенние, зимние или весенние месяцы.
Еще одно различие было выявлено между штаммами, поражающими людей, проживающих в сельской и городской местности. Заражение энтеритом, как правило, выше в сельской местности. Это может быть связано с тем, что сельские жители контактируют с сельскохозяйственными животными или используют неочищенные источники воды.
Население сальмонеллы в каждом штате имеет свою индивидуальность; поэтому подход каждого штата к выявлению факторов, вызывающих заболевания, и эффективных методов лечения должен быть изменен с учетом этих особенностей.
«Наши результаты показывают важность эпиднадзора, мониторинга частоты резистентности и выявления факторов риска, характерных для каждого штата и региона», - сказал Мэннинг. «Выявленные тенденции могут привести к новым стратегиям предотвращения».